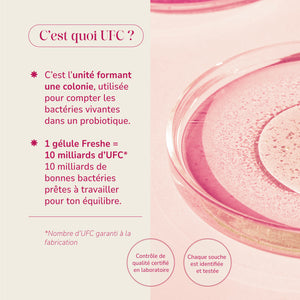
Freshe Intima Spécial flore intime

j’avais peur d’avoir une mycose après mes antibiotiques, mais Intima Plus m’a sauvée 🙏
Produit reçu en 2 jours, je commence ma cure
Après 3 semaines, beaucoup moins d’inconfort et mon équilibre est revenu. Je recommande à 100% !
Ca fait 2 semaines que je le prend. Ca a l'air de soulager mes genes pendant la SPM. Je vais continuer la cure on verra